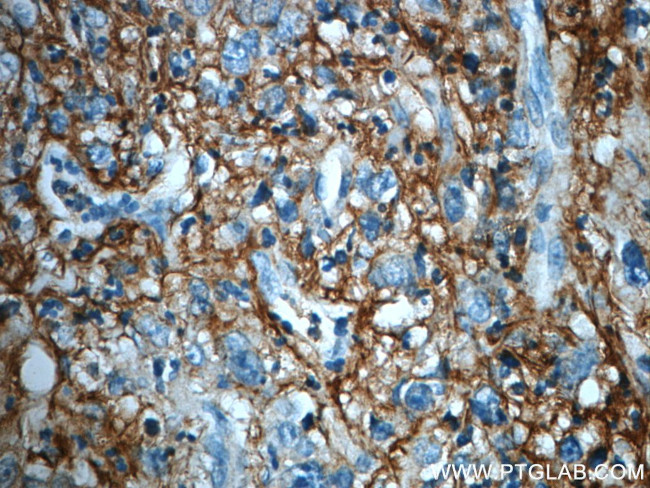
ITIH3 Antibody in Immunohistochemistry (Paraffin) (IHC (P))

Search
Proteintech
ITIH3 Polyclonal Antibody
{{$productOrderCtrl.translations['antibody.pdp.commerceCard.promotion.promotions']}}
{{$productOrderCtrl.translations['antibody.pdp.commerceCard.promotion.viewpromo']}}
{{$productOrderCtrl.translations['antibody.pdp.commerceCard.promotion.promocode']}}: {{promo.promoCode}} {{promo.promoTitle}} {{promo.promoDescription}}. {{$productOrderCtrl.translations['antibody.pdp.commerceCard.promotion.learnmore']}}
产品信息
21247-1-AP
种属反应
已发表种属
宿主/亚型
分类
类型
抗原
偶联物
形式
浓度
规格
纯化类型
保存液
内含物
保存条件
运输条件
产品详细信息
Immunogen sequence: MVVTKPEDN EDERAIADKP GEDAEATPVS PAMSYLTSYQ PPQNPYYYVD GDPHFIIQIP EKDDALCFNI DEAPGTVLRL IQDAVTGLTV NGQITGDKRG SPDSKTRKTY FGKLGIANAQ MDFQVEVTTE KITLWNRAVP STFSWLDTVT VTQDGLSMMI NRKNMVVSFG DGVTFVVVLH QVW (601-782 aa encoded by BC107604)
靶标信息
This gene encodes the heavy chain subunit of the pre-alpha-trypsin inhibitor complex. This complex may stabilize the extracellular matrix through its ability to bind hyaluronic acid. Polymorphisms of this gene may be associated with increased risk for schizophrenia and major depressive disorder. This gene is present in an inter-alpha-trypsin inhibitor family gene cluster on chromosome 3.
仅用于科研。不用于诊断过程。未经明确授权不得转售。
生物信息学
蛋白别名: inter-alpha (globulin) inhibitor H3; inter-alpha (globulin) inhibitor, H3 polypeptide; inter-alpha-inhibitor H3 chain; inter-alpha-inhibitor heavy chain 3; Inter-alpha-trypsin inhibitor heavy chain H3; ITI heavy chain H3; ITI-HC3; pre-alpha (globulin) inhibitor, H3 polypeptide; pre-alpha-inhibitor heavy chain 3; pre-alpha-inhibitor, heavy chain 3; Serum-derived hyaluronan-associated protein; SHAP; unnamed protein product
基因别名: AW108094; H3P; Intin3; ITI-HC3; Itih-3; ITIH3; PAIHC3; SHAP
UniProt ID: (Human) Q06033, (Mouse) Q61704, (Rat) Q63416
Entrez Gene ID: (Human) 3699, (Mouse) 16426, (Rat) 50693